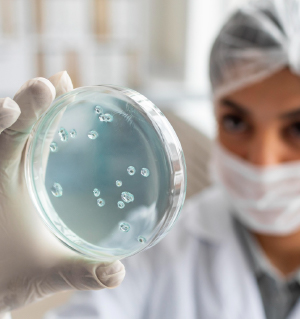

IMPELAB ANALYSE
Des analyses fiables
pour garantir la sécurité et la qualité de vos produits alimentaires
Chimie & Microbiologie
Chez IMPELAB, nous mettons à votre disposition un laboratoire moderne et accrédité, spécialisé en analyses chimiques et microbiologiques.
Nos services
Analyses microbiologiques
détection et dénombrement des germes pathogènes (Salmonella, Listeria, E. coli…), analyses d’hygiène (flore totale, levures, moisissures, coliformes, etc.).

Analyses chimiques
recherche de résidus (pesticides, antibiotiques, métaux lourds), contrôle nutritionnel, additifs, contaminants.

Prélèvements
réalisés par nos techniciens qualifiés directement sur vos sites de production, de stockage ou de distribution.

Rapports clairs et exploitables
résultats interprétés avec recommandations pratiques.
Valeur ajoutée
Assurer la conformité de vos produits, protéger la santé des consommateurs et vous accompagner dans le respect des exigences réglementaires nationales et internationales.
Contact
Email Address
contact@impelab.com
Appelez Nous
+212 524 336 378
Addresse
Quartier Industriel Sidi Ghanem 3, Lot N7 Route de Safi, Marrakech